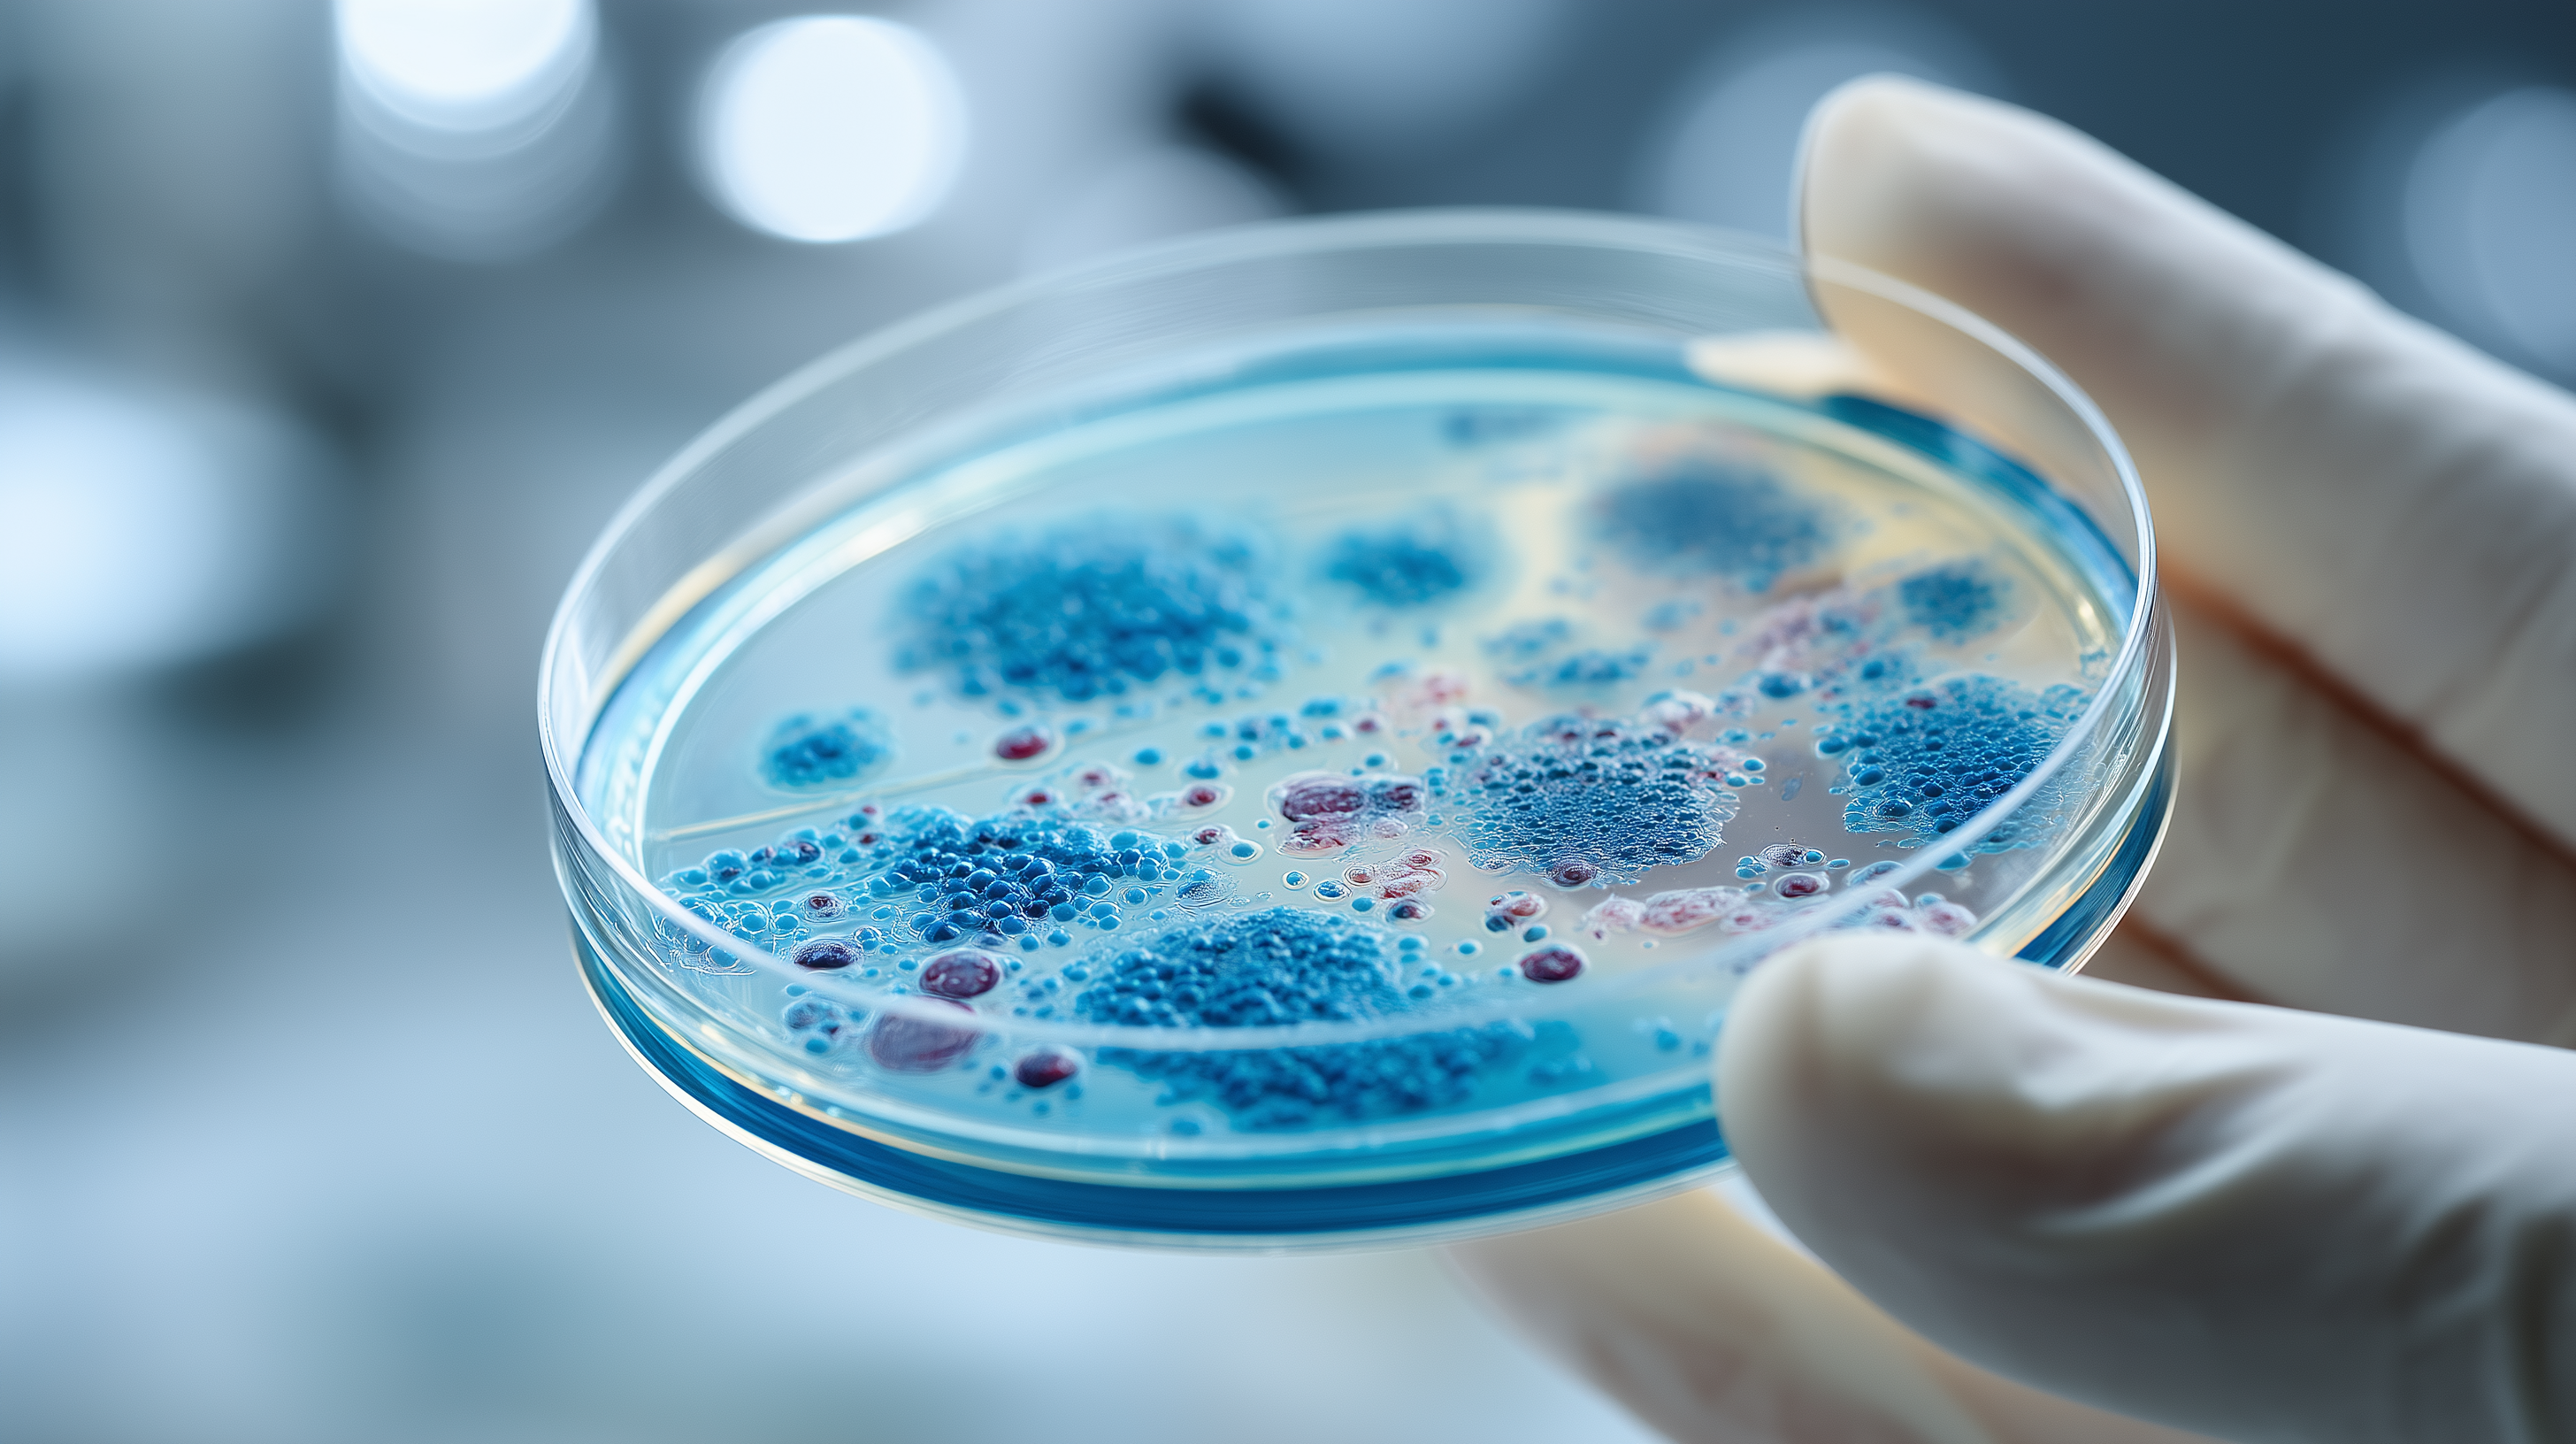

Welcome to Future Tech Insight
Embark on a journey into the future with Future Tech Insight your premier source for exploring the science and technology that will define our world. We provide insightful analysis on AI robotics quantum computing biotechnology nanotechnology space exploration and more. Prepare to be inspired as we delve into the potential and possibilities of tomorrow.
Unveiling the Pillars of Tomorrow's World
Future Tech Insight illuminates the realm of robotics and automation exploring how these technologies are transforming industries and daily life. Discover the latest advancements in robotic design AI-powered automation and their potential impact on productivity efficiency and the future of work.
At Future Tech Insight we unravel the complexities of nanotechnology showcasing its potential to create revolutionary materials devices and solutions. Explore how nanotechnology is impacting fields such as medicine electronics energy and environmental science paving the way for unprecedented technological advancements.
Future Tech Insight takes you on a journey through space exploration highlighting the latest missions discoveries and technological advancements. Learn about the quest to explore distant planets search for extraterrestrial life and unlock the secrets of the universe inspiring future generations of scientists and explorers.
A Glimpse into the World of Tomorrow




Step into the Realm of Future Tech!
At Future Tech Insight explore the cutting-edge advancements in science and technology that are poised to revolutionize our future. From biotechnology to space exploration discover how these innovations will impact society and redefine the human experience.
Unveiling the technological landscape of tomorrow
FUTURE NOW
EMBRACE BIOTECH , NANOTECH , AND SPACE EXPLORATION THAT
REDEFINE HUMANITY
Nanotechnology's Microscopic Marvels
Explore the potential of nanotechnology to create revolutionary materials devices and solutions with applications across various industries.


